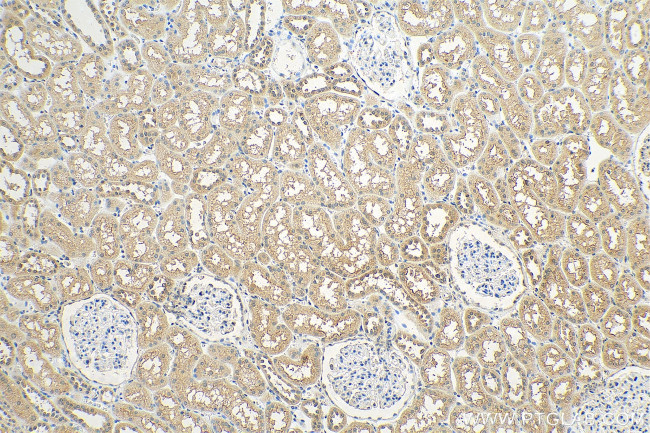
OTUD4 Antibody in Immunohistochemistry (Paraffin) (IHC (P))

Search
Proteintech
OTUD4 Polyclonal Antibody
{{$productOrderCtrl.translations['antibody.pdp.commerceCard.promotion.promotions']}}
{{$productOrderCtrl.translations['antibody.pdp.commerceCard.promotion.viewpromo']}}
{{$productOrderCtrl.translations['antibody.pdp.commerceCard.promotion.promocode']}}: {{promo.promoCode}} {{promo.promoTitle}} {{promo.promoDescription}}. {{$productOrderCtrl.translations['antibody.pdp.commerceCard.promotion.learnmore']}}
产品信息
25070-1-AP
种属反应
宿主/亚型
分类
类型
抗原
偶联物
形式
浓度
规格
纯化类型
保存液
内含物
保存条件
运输条件
产品详细信息
Immunogen sequence: DAHFPMQTE ASVNGQMPQP EIGPPTFSSP LVIPPSQVSE SHGQLSYQAD LESETPGQLL HADYEESLSG KNMFPQPSFG PNPFLGPVPI APPFFPHVWY GYPFQGFIEN PVMRQNIVLP SDEKGELDLS LENLDLSKDC GSVSTVDEFP EARGEHVHSL PEASVSSKPD EGRTEQSSQT RKADTALASI PPVAEGKAHP PTQILNRERE TVPVELEPKR TIQSLKEKTE KVKDPKTAAD VVSPGANSVD SRVQRPKEES SEDENEVSNI LRSGRSKQFY NQTYGSRKYK SDWGYSGRGG YQHVRSEESW KGQPSRSRDE GYQYHRNVRG RPFRGDRRRS GMGDGHRGQH T (764-1113 aa encoded by BC118653)
靶标信息
OTUD4 alternatively spliced transcript variants have been found for this gene. The smaller protein isoform encoded by the shorter transcript variant is found only in HIV-1 infected cells.
仅用于科研。不用于诊断过程。未经明确授权不得转售。
生物信息学
蛋白别名: Hin-1; HIV-1 induced protein HIN-1; HIV-1-induced protein HIN-1; OTU domain-containing protein 4; unnamed protein product
基因别名: DUBA6; HIN-1; HIN1; HSHIN1; KIAA1046; OTUD4
UniProt ID: (Human) Q01804
Entrez Gene ID: (Human) 54726